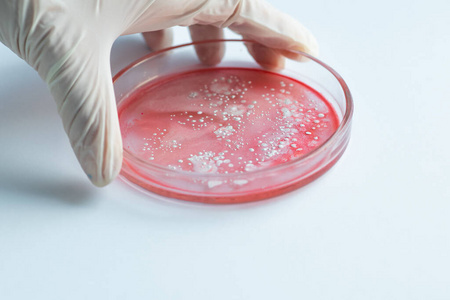
研究病毒和细菌时,研究人员拿着一个装有样本的培养皿.照片

病毒培养

病毒的细胞培养 细胞培养瓶 单层细胞
图片尺寸1080x810
病毒和细菌竟有这么多不同!
图片尺寸640x426
因为病毒需要在活体细胞(一般用鸡蛋)中培养好几个月.
图片尺寸660x440
越来越多的病毒和细菌细胞的培养皿.酱香酒
图片尺寸1023x682
研究病毒和细菌时研究人员拿着一个装有样本的培养皿
图片尺寸700x467
邢台市疾控中心首次用鸡胚培养法分离出流感病毒
图片尺寸1080x609
中国疾控中心:北京新冠聚集性疫情病毒分离培养成功
图片尺寸1280x720
越来越多的病毒和细菌细胞的培养皿.微生物
图片尺寸1024x713
但是要想培养病毒,必须接种在活的细胞上
图片尺寸536x400
实验方法原理:组织培养是目前培养病毒
图片尺寸361x240
研究病毒和细菌时研究人员拿着一个装有样本的培养皿
图片尺寸700x467
岗位上的劳动者培养新冠病毒的人
图片尺寸1200x1600
新型冠状病毒相关
图片尺寸600x399
我国又一个新冠病毒疫苗附条件上市
图片尺寸4816x3211
研究病毒和细菌,研究人员拿着一个带有样本的培养皿.
图片尺寸1200x675
细菌病毒的培养皿甲醛,tvoc指数超标的儿童房,亦是家长们头疼的另一个
图片尺寸550x368
研究病毒和细菌时,研究人员拿着一个装有样本的培养皿.照片
图片尺寸450x300
2,实验室检查:病毒培养,核酸检测,抗体检测或者细胞学检查可以帮助
图片尺寸600x400
资料图片:细菌培养基
图片尺寸379x256
流感病毒分离无血清培养基
图片尺寸660x451